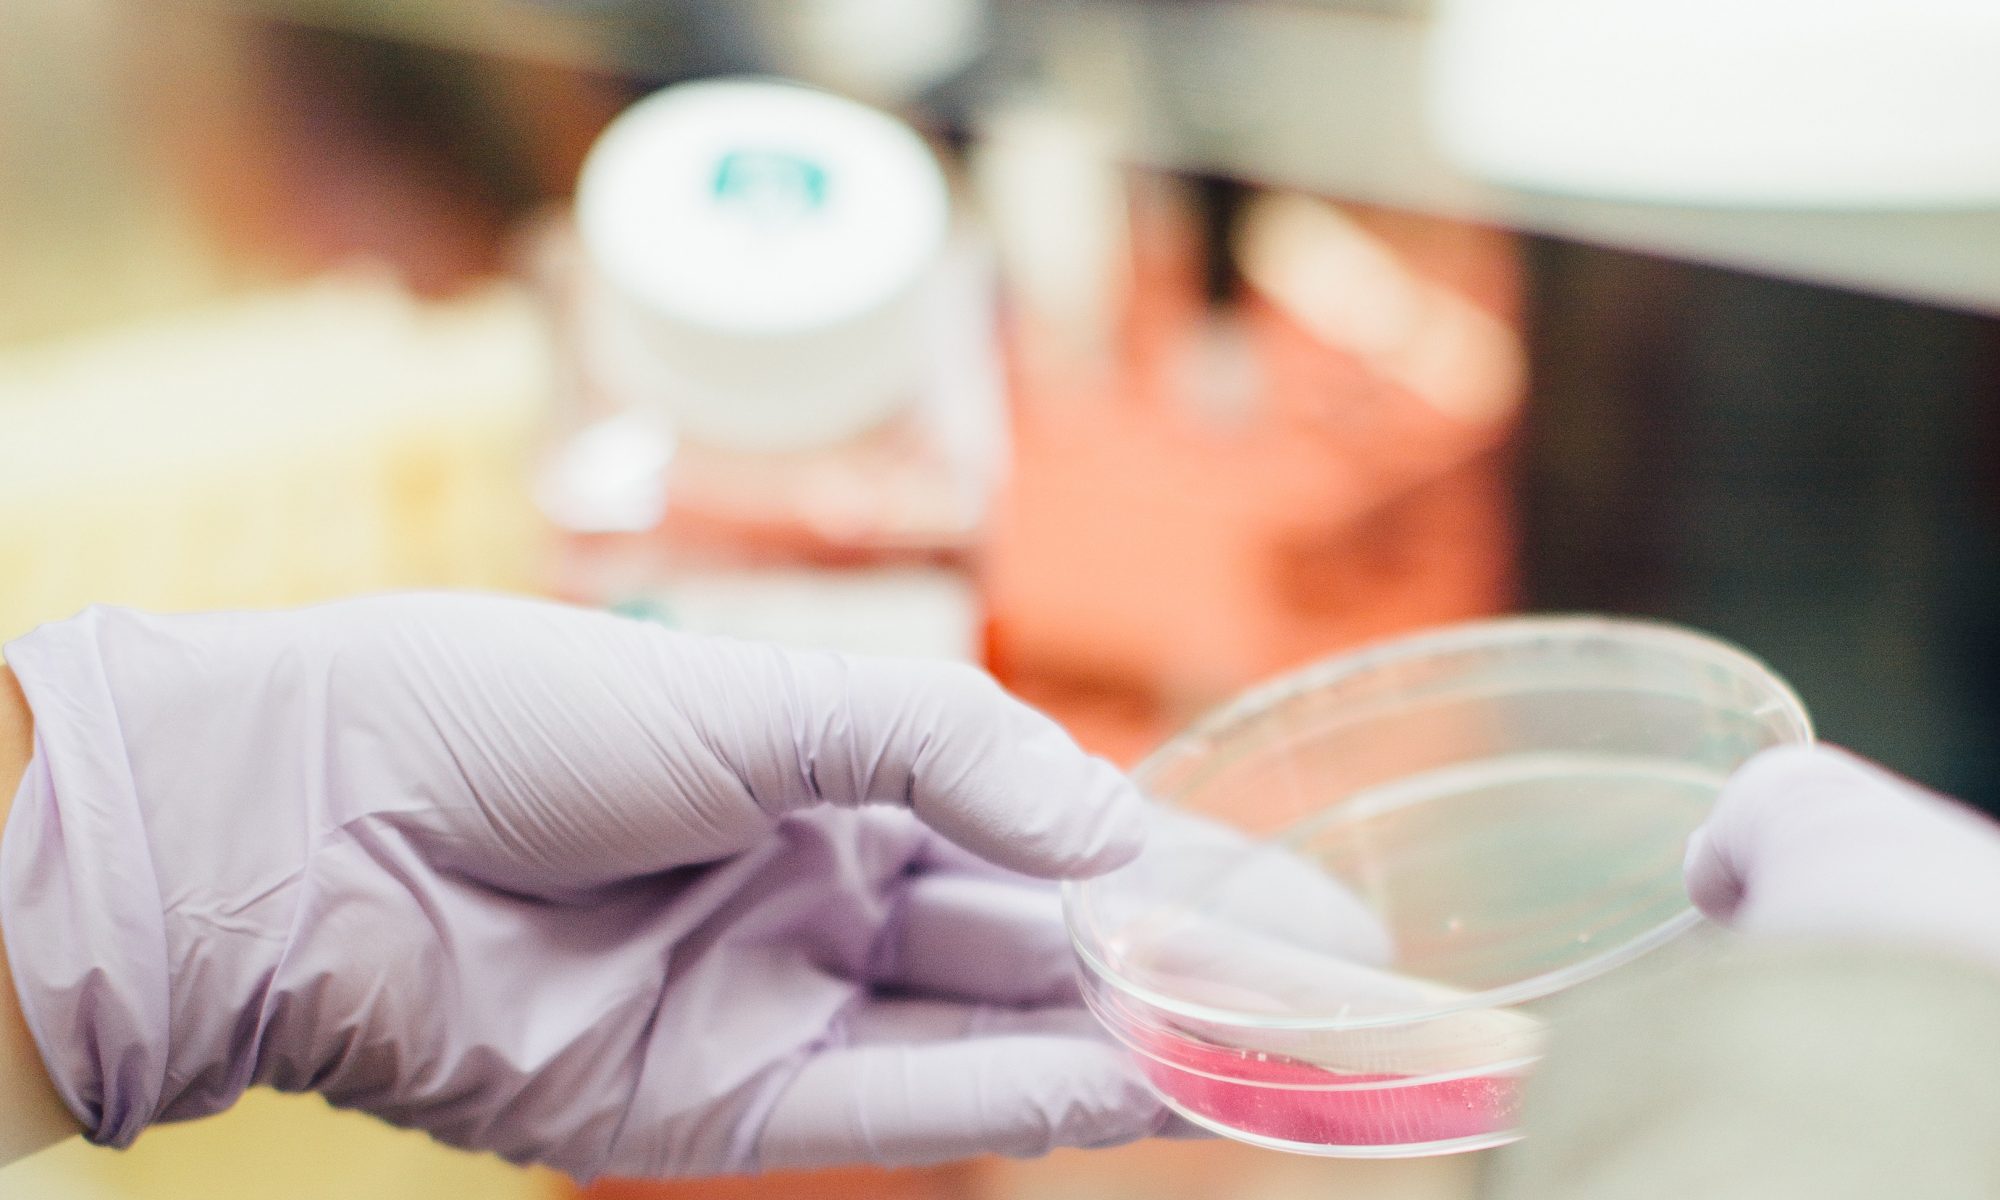

La escasez y falta de estas unidades es otro factor a tener en cuenta para organizar un sistema sanitario capaz de responder al presente y al futuro de los pacientes con diabetes independientemente de nuevas terapias como la que ahora comentaremos.
A partir de todos estos datos fue surgiendo la idea de una terapia que pudiera aplicarse a gran cantidad de pacientes y desde los estudios de Yuyama en 2002 se observó que la aplicación de la terapia con células madres seria una alternativa posible en este siglo si éramos capaces de desarrollarla.
La terapia con células madres o stem cells está en pleno desarrollo después de diversos estudios realizados en estos últimos años. Los estudios se han realizado con células madre adultas tomadas de la médula ósea de los pacientes o de su propia grasa y aplicados por diferentes vías en los mismos, destacando las vía intramuscular e intrarterial como las más efectivas.
En el caso de los pacientes con diabetes se han aplicado a pacientes con pie diabético y también a pacientes que no padecen la enfermedad, considerados como no revascularizables por sus lesiones arteriales dístales.
En este momento los estudios se han realizado hasta completar la fase II de los ensayos de investigación lo que ha demostrado la seguridad y la factibilidad del tratamiento, considerado como un medicamento, lo que pone de manifiesto la ausencia de posibles efectos no deseados en los pacientes sometidos a esta terapia innovadora. En nuestro país hemos realizado varios ensayos clínicos con pacientes con y sin diabetes obteniendo resultados favorables y sobre todo muy esperanzadores para las personas que padecen diabetes sin vascularización distal o muy pobre y por tanto con alto riesgo de amputación y pocas opciones de salvar la extremidad afectada cuando llegan las complicaciones graves de infección e isquemia arterial.
Estos estudios, los hemos completados además con una serie de casos compasivos, cuyos resultados fueron y son, favorables y por tanto podemos decir que la mayoría de los pacientes tratados en ensayos y con carácter compasivo han mejorado tras nueve años de investigación y seguimiento.
Además han cicatrizado las lesiones en los pacientes con mayor grado de afectación por úlceras o lesiones tróficas y aquéllos que presentaban una isquemia arterial, también mejoraban desapareciendo su dolor de reposo e incluso llegando con el tiempo, a dejar de claudicar en numerosos casos gracias al proceso de angiogénesis en la zona distal de la extremidad afectada y tratada con células madre adultas. En este momento podemos llegar a conseguir que los pacientes salven sus extremidades y logren mejorar las posibles complicaciones derivadas de una diabetes mal llevada , pero también hay que afirmar que estamos desarrollando un estudio definitivo en fase III que corrobore los resultados observados en los ensayos y casos compasivos ya finalizados. En nuestra opinión los pacientes con diabetes deben tener especialistas médicos y de enfermería dedicados al pie diabético en sus diferentes aspectos para la cura de sus lesiones en unidades de curas y ulceras donde se desarrolle el diagnóstico y tratamiento adecuado, todo ello necesario para el salvamento de extremidades en aquellos pacientes en los que no se pueden realizar las técnicas endovasculares distales o la cirugía distal
La terapia con células madre es sin duda un procedimiento que no solo puede sustituir a otros sino coexistir y complementar a los existentes, de modo que puede ser salvaguarda de las graves complicaciones del pie diabético isquémico, pero estamos seguros que a corto plazo su indicación será mucho mas que una alternativa, una profilaxis que se pueda emplear en un gran numero de pacientes de acuerdo a la prevalencia esperada de estos pacientes en los próximos años. La década de estudio que llevamos con esta terapia aplicada a los pacientes con isquemia crítica nos indica que las ventajas del procedimiento a largo plazo en los pacientes tratados son evidentes y vuelven a darnos un impulso para continuar en este sentido investigando y aplicando los conocimientos derivados de nuestra experiencia en España y exportándola al resto de la comunidad científica internacional.